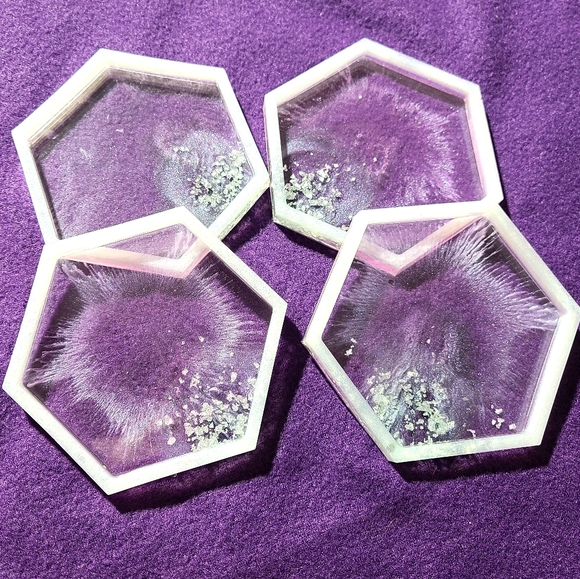
Coasters - Picture 1 of 1

Coasters
Boutique
$18 $25
Size
Like and save for later
Add To Bundle
These are chic and classy for any room to protect your tables! Can be used for drinks, candles, or anything else!
From Two Blessed Boutique
Shipping/Discount

what1ever
likes this
Trending Now
Find Similar Listings
Account is under Review
Comment posting is temporarily restricted. Our team will reach out to you shortly. To understand why, select
Learn More.